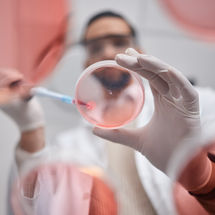
Garantizar la seguridad farmacéutica con las pruebas de ...
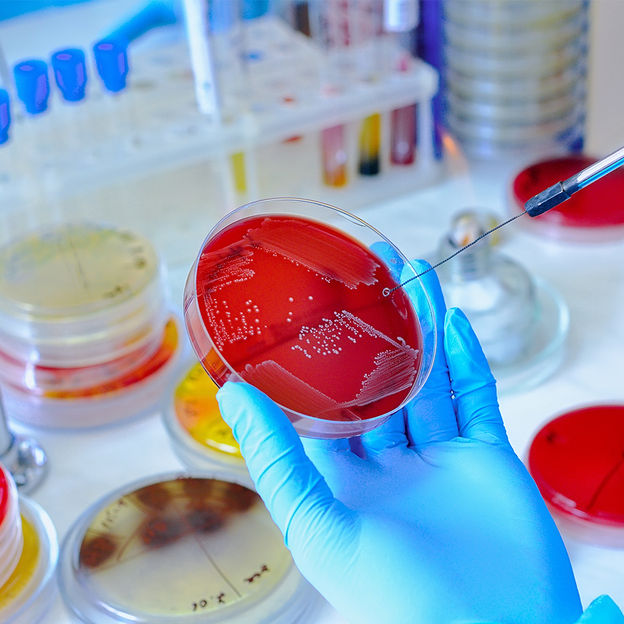
Aislamiento e identificación de patógenos clínicos

Redipor - Ready to use media
Medios de cultivo preparados para controlar, probar y validar entornos y productos
Rendimiento en el que puede confiar. Producido bajo las acreditaciones ISO 9001 e ISO/IEC 17025
A medida y adaptados a su finalidad. Flexible en formulaciones, volúmenes de llenado, envasado y formatos estériles.
Suministro y asistencia fiables con producción en varios centros para una entrega rápida y continuidad empresarial










Soluciones a medida de alta calidad para el control de calidad de productos farmacéuticos, alimentos, bebidas, agua y diagnóstico clínico
Nuestros medios de cultivo listos para usar ofrecen a los laboratorios de las industrias de control de calidad farmacéutica, análisis de alimentos y bebidas, análisis de aguas y diagnóstico clínico soluciones fiables, eficaces y prácticas para los análisis microbiológicos. Ahorran un tiempo valioso, ya que no es necesaria ninguna preparación, y reducen el riesgo de contaminación con medios ya probados y preparados. Esto garantiza unos resultados uniformes y precisos que cumplen las normas de calidad y los requisitos normativos más exigentes.
La flexibilidad de los medios permite integrarlos perfectamente en diversos flujos de trabajo de laboratorio, desde pruebas rutinarias hasta aplicaciones especializadas. Tanto si se necesitan lotes pequeños para pruebas específicas como volúmenes mayores para las operaciones diarias, los medios permiten una planificación y ejecución eficaces de los análisis.
La trazabilidad y la calidad estandarizada garantizan resultados reproducibles y simplifican el cumplimiento de la normativa. En el sector farmacéutico, ayudan a detectar la contaminación en una fase temprana y garantizan la producción de productos seguros y conformes. En las pruebas de alimentos y bebidas, permiten la detección rápida de patógenos, el control de la higiene y la validación de procesos para proteger a los consumidores y mantener la calidad de los productos.
En los análisis de aguas, los medios proporcionan una base fiable para detectar microorganismos nocivos y garantizar el cumplimiento de las normas reglamentarias, apoyando la supervisión de los sistemas de aguas industriales y medioambientales. Los laboratorios pueden realizar incluso las pruebas más exigentes con rapidez y precisión.
Además, los medios listos para usar simplifican las operaciones de laboratorio al reducir el tiempo de preparación, las necesidades de equipos y los requisitos de formación del personal. Esto minimiza los errores y el riesgo de contaminación, al tiempo que mejora la productividad y la eficiencia del flujo de trabajo.
En resumen, estos medios de cultivo proporcionan resultados seguros y reproducibles, aumentan la eficacia, reducen los riesgos y ayudan a los laboratorios a cumplir de forma fiable las estrictas normas reglamentarias y de calidad. Son la solución ideal para los laboratorios que exigen pruebas microbiológicas precisas, seguras y eficientes.
Nota: Este artículo ha sido traducido automáticamente. LUMITOS ofrece este servicio para que la información del producto esté disponible en más idiomas. Como este artículo se ha creado automáticamente, es posible que haya errores y desviaciones respecto al original. La presentación original en Inglés puede encontrarse aquí.

1
Redipor by AnalytiChem - Gama de productos
2
Garantizar la seguridad farmacéutica con las pruebas de esterilidad de Redipor

3
Los análisis microbianos son fundamentales para la seguridad alimentaria

4
Análisis del agua
5
Aislamiento e identificación de patógenos clínicos
Solicitar información sobre Redipor - Ready to use media

Medios de cultivo: Redipor - Ready to use media
Medios de cultivo preparados para controlar, probar y validar entornos y productos


